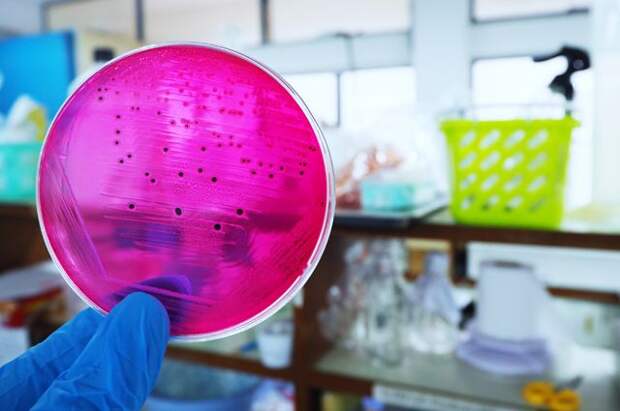

Одно из самых распространённых опасений — кишечные инфекции, в том числе сальмонеллёз. «АиФ» решил разобраться и развенчать мифы, связанные с этим заболеванием.
На вопросы читателей отвечает доктор биологических наук, профессор Наталья Белушкина.
Что такое сальмонеллёз?
А. Светлова, Курск
— Сальмонеллёз — острое кишечное заболевание, которое вызывают сальмонеллы — палочковидные микробы, открытые в XIX в.
американским ветеринаром Даниелем Элмером Салмоном. Содержать сальмонеллы может любая сырая пища животного происхождения (мясо, птица, молоко, морепродукты, яйца), а также растительная продукция — некоторые виды овощей и фруктов. Всего существует 2,3 тыс. серотипов этих бактерий, однако наиболее распространёнными являются только два из них.Сальмонеллы содержатся только в продуктах питания?
К. Вихрова, Вел. Новгород
— Нет. Сальмонеллы распространены повсеместно и есть абсолютно в любой квартире, поскольку бактерии быстро переносятся и легко «кочуют» с продуктов на предметы окружающего быта. Один из самых распространённых путей — перенос микробов после разделки продуктов с доски на любые другие предметы кухни и квартиры: ручки дверей, водопроводные краны, а оттуда на предметы быта и даже на детские игрушки.
Каковы симптомы сальмонеллёза? Насколько стоит опасаться болезни?
А. Хрипун, Когалым
— Сальмонеллёз — инфекционная болезнь, опасность и вред которой зачастую преувеличивают. Болезнь может протекать по-разному — у некоторых людей симптомы никак не видны, у других болезнь проявляется в виде диареи, судорог в животе, головной боли. Как правило, это происходит спустя 7–8 часов после употребления загрязнённой пищи.
Обычно симптомы исчезают в течение 4–7 дней; многие люди с сальмонеллёзом восстанавливаются без лечения и не посещают врача по этому поводу. В то же время надо отметить, что более других сальмонеллёз опасен для младенцев и детей раннего возраста, беременных женщин, пожилых людей и людей с ослабленной иммунной системой.Считается, что одним из основных источников заболевания является мясо птиц. Так ли это? Если употреблять в пищу фермерскую птицу, не промышленного производства, опасность сальмонеллёза ниже?
Т. Васильева, Омск
— В случае с мясом птицы нет никакой достоверной научной информации, свидетельствующей о том, что конкретный вид курицы (так называемая фермерская, органическая или птица промышленного производства) более других подвержен бактериям сальмонеллы. Однако надо иметь в виду, что продукция от частного фермера может привести к неоправданно высоким рискам, так как в России до сих пор не существует системы полноценной оценки качества фермерских продуктов.
Заражение продукции сальмонеллой — следствие недостаточного контроля со стороны производителя?
А. Истомина, Благовещенск
— Совсем необязательно! Очень часто сальмонеллёз в мясной или растительной продукции возникает вследствие её неправильного хранения и/или транспортировки. Несоблюдение температурного режима при перевозке или в торговом зале приводит к порче продукции, поскольку сальмонеллы быстро размножаются в тепле. Поэтому при посещении магазинов обязательно обращайте внимание на условия хранения продуктов! Нередко паллеты с мясной или молочной продукцией находятся непосредственно в залах магазина или их не спешат разгружать в необходимые сроки.
Какие рекомендации вы можете дать нашим читателям, как избежать сальмонеллёза?
Ю. Ватутина, Балашиха
— Если мы говорим о мясной продукции, бактерии сальмонеллы погибают при высоких температурах и неопасны для человека. Поэтому одна из главных рекомендаций — достаточная термообработка: при длительном тепловом воздействии вредные бактерии разрушаются. Не употребляйте в пищу недостаточно прожаренное мясо, рыбу или яйца — это прямая опасность заражения. Тщательно мойте овощи и фрукты.
Кроме того, необходимо соблюдать простые правила на кухне — использовать разные разделочные доски для разных типов продуктов, тщательно мыть со специальным средством разделочные поверхности и ножи. Важно не допускать перекрёстного хранения продуктов. Ведь бактерии могут также загрязнять другие продукты — например, когда соки из сырого мяса или птицы соприкасаются с готовыми к употреблению продуктами: салатами или фруктами. Не стоит пренебрегать и классическим советом: «Мойте руки перед едой!» Ведь пища может быть заражена плохо вымытыми руками при готовке или сервировке стола. Дома также не забывайте о температурных правилах хранения продуктов — надо положить их в холодильник как можно быстрее. Температура хранения должна составлять максимум +6 градусов Цельсия. Если вы готовите из замороженных продуктов, оттаивайте их в холодильнике, в холодной воде или в микроволновке. Продукты нельзя оттаивать при комнатной температуре.
Все эти правила достаточно простые, и от их соблюдения зависят ваше здоровье и самочувствие.
Свежие комментарии